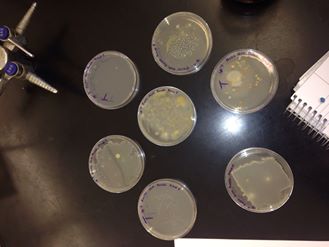
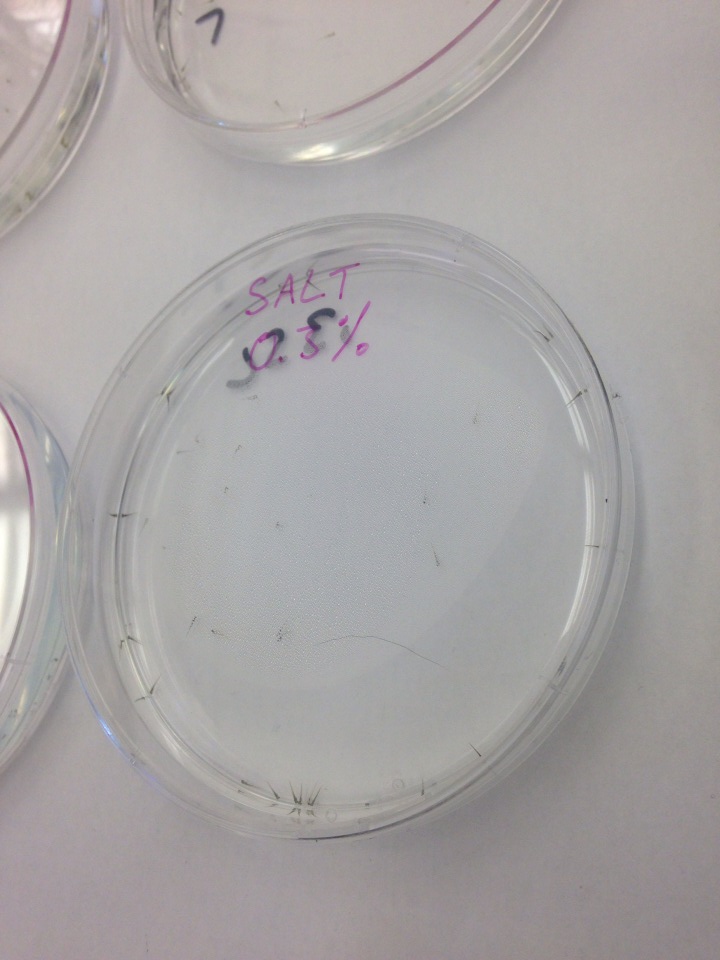

User:Pamela Huber/Notebook/Biology 210 at AU
Lab 1 Part 1: Observing Evolution in the Volvicine Line
The purpose of this experiment is to observe evolution in the volvicine line by observing and recording the characteristics of Chlamydomonas, Gonium, and Volvox. The first organism began the evolution of the volvicine line. Gonium evolved from Chlamydomonas, and Volvox came last in the line, evolving from Gomium. All information filled into the chart below is based on the reading provided for the lab, not on direct observation. Therefore, there are no drawings of the prepared slides for this lab. Had this part of the lab been completed, the steps would be: 1) Prepare a slide of living Chlamydomonas and observe it with a microscope, adding protoslo if the organisms were too motile to observe. Draw what is observed. 2)Prepare a slide of living Gonium and observe it with a microscope, adding protoslo if the organisms were too motile to observe. Draw what is observed. 3) Prepare a slide of living Volvox and observe it with a microscope, adding protoslo if the organisms were too motile to observe. Draw what is observed.
Table 1: Evolutionary Specialization of Members of the Volvocine Line
Chlamydomonas: single-celled, colony size N/A, has specialized flagella and chloroplasts, isogamy
Gonium: 4-32 cells per colony, colony size N/A, cells held in a gelatinous mixture, isogamy
Volvox: thousands of cells per colony, colony size N/A, specialized spiked cells held in spherical colonoy, specialized reprodictive cells = oogamy
Conclusions:
What is the significance of cell specialization across these three genera?
Cell specialization coincides with how complex each of the three genera are. The more cells an organism has, the larger and the more complex that organism is. The more complex an organism is, the more specialized its cells can be, allowing it to thrive in more diverse environmental circumstances.
Does evolution always move towards increased complexity? Provide an example to support your answer.
For bacteria, evolution does always lead towards increased complexity, as seen by the growing size from Chlamydomonas being a single cell to the multiple cells in Gonium and thousands of cells in Volvox. More cells allows a colony to selectively specialize; the more cells an organism has, the more cell specialization possible, and the more complex functions the organism can perform. The evolution from Gonium to Volvox showed a thousand percent increase in the numebr of cells; the multi-fold increase in cells allowed for reproductive specialization, wherein Volvox reproduces sexually rather than asexually.
Part II: Defining a Niche at AU The purpose of this experiment is to understand the concepts of niches, populations, species, communities, ecosystems, biotic organisms, and abiotic components of specific environments. Different niches, identified by different 20 by 20 feet transects of land on AU's campus, have different environments, determined by their abiotic and bitoic factors. The transect will provide species of protists, bacteria, animals, and plants for observing in further experiments. To observe the transect and collect a sample for further experiemnts: 1) Go to the 20 by 20 foot transect of land marked "5" on the AU campus. 2) Observe the characteristics of the transect, including where it is locate and a drawing of its topography. 3) Record the abiotic and biotic components of the transect. To study the 4) Take a sample of dirt and leaves from the transect and place it in a 50 mL canonical tube. 5) Measure out 10 grams of the dirt and leaves from the transect sample and place it in a plastic jar with 500 Mls of Deerpark water and .1 grams of dried milk. Mix the components for 10 seconds. 6) Seal and label the jar Group 5 for the #5 transect.
Notes:
The #5 transect is located on the quad to the right of the Hurst Building.
The topography is flat with cement walkways that border grass and plant mulch-beds.
The abiotic components of the transect include cement, a cement bench, rocks, a temperate climate and cold temperature, and snow melting on the ground.
The biotic components of the transect include grass, rosebushes, decaying leaves, moss, and wood chips. Presumably many insects, protists, and bacteria lives within the soil and on the plants; but none were directly observed.
Figure 1: Transect 5 Photograph

Conclusions and Future Plans: The hay culture infusion in the plastic jar will be used in future experiments. The dried milk will serve as nutrients for protists and bacteria to grow in the infusion.
The transect niche consists of abiotic and biotic elements which make up an ecosystem. The ecosystem of this transect may differ from the ecosystems of other transects, making each one a different niche of the overall ecosystem of AU's campus. The biotic elements of the transect encroach and grow on or around the abiotic elements which are immobile. The immobile abiotic components take up room where biotic organisms could live, thereby limiting biotic reproduction. The decaying matter of biotic organisms, such as the dead leaves, act as nutrients for living biotic organisms, such as the grass. The climate affects the biotic organisms directly; rain gives organisms nutrients, while an arid climate would dry out the rosebushes and grass. Snow melts and offers nutrition to biotic organisms, particularly the grass and rosebushes.
Excellent start. Good description of task undertaken and some analysis and conclusions. SK
Lab 2
The purpose of this experiment is to learn how to use a dichotomous key to identify organisms by using one in identifying free-living protozoa in our hay infusion cultures from Lab 1.
Procedure:
1) Take samples of organisms in the hay infusion culture from two niches in the culture: one near the surface of the water and one near the plant matter at the bottom of the water.
2) Prepare two slides with a drop of liquid from one of the niches onto microscope slides with cover slips on top.
3) Draw pictures of the organisms observed.
4) Characterize as many organisms as possible from each slide; three per slide are preferred. Identify the organisms using the dichotomous key.
Results:
While many organisms are observed, only two single-celled species could be recognized as separate from one another; these two were both identified as protists.
Organism 1:

15 ocular micrometers wide and 20 ocular micrometers long at 100X magnification.

10 ocular micrometers wide and 15 ocular micrometers long at 40x magnification.
Based on the dichotomous key, this organism is the protist Euplotes
Organism 2:

40 ocular micrometers long at 40X magnification.

10 ocular micrometers long at 10X magnification.
Based on the dichotomous key, this organism is Bursaria truncatella.
Conclusions:
How Bursaria truncatella meets the requirements for life:
Bursaria truncatella has a large, wide mouth. This mouth would be used to ingest food it comes in contact with, indicating that it metabolizes heterotrophically obtained food.
As a unicellular organism without specialized sex cells, the protist must engage in asexual reproduction. Since this species is only one cell, it does not grow by dividing and forming specialized cells, but rather during mitosis as it is formed.
The species moves by using cilia covering its body.
The species responds to its environment by using cilia to move it around large objects such as plant matter; the species was not observed going into or over the plant matter, simply around the edges.
If the hay infusion culture was not observed for another two months, I would predict that more organisms could be found due to reproduction, and that more organisms would be visible to the naked eye as they would have more time to grow or form colonies.
The selective pressures that affected the decomposition of my samples included the amount of food available (the dried milk) and shelter for those that live around the plant matter, as limited edge space limits how many protists can grow there.
Additionally, we had to prepare a serial dilution of the hay infusion culture for Lab 3. Here is a drawing of the procedure, with the jar representing the original hay infusion culture and each successive tube moving towards the right representing a more diluted sample of the culture. The first three solutions were applied to regular agar plates and agar plus tetracycline plates; the fourth dilution was only applied to a regular agar plate.

Lab 3
The purpose of this experiment is to learn how to identify microorganisms such as bacteria by observing their properties. Some specific properties used to identify bacteria are antibiotic resistance and DNA sequencing.
Prediction:
These predictions are based on the diluted agar nutrient and T-treated plates made last week in lab. We predict that the least diluted agar plates that are not T-treated will have the most colonies. We also predict that each nutrient agar plate will have more colonies that its T-treated counterpart of the same dilution.
Part 1:
The purpose of this procedure is to quantify the colonies on the different dilutions of the agar petri dishes to help draw final conclusions about colony growth.
Results:
The hay infusion culture is darker than last week and smells more strongly of dirt. A reason for this could be that the bacteria in the culture continued to reproduce over the last week, causing a more pungent release of waste and other bi-products.
Table 1: 100-Fold Serial Dilution Results

Figure 1: The 7 agar petri dishes:
Part 2:
The purpose of this procedure is to draw conclusions about antibiotic resistance in bacteria to help draw final conclusions about colony growth.
Results:
The quantitative results of bacteria growth in the presence of tetracycline can be found in Table 1.
Conclusions:
Far fewer colonies grew on the nutrient and Tet-treated agar plates than the pure nutrient plates. The colonies that grew on the Tet-treated plates were circular, while the colonies that grew on the nutrient plates were circular and filamentous and had distinct edging patterns that were either undulate or lobate edges. This indicates that the Tet-treated plates not only have an overall fewer number of colonies grow, but that only certain species of bacteria grow in the Tet-treated plates.
The effect of tetracycline on the total number of fungia nd bacteria is that it reduces the number of bacteria by a lot. The difference between the 10^-7 nutrient plate and the 10^-7 Tet-treated plate was at least a twelvefold diminishment.
At least 3 species are unaffected by tetracycline, because three morphologically different colonies were visible in the Tet-treated plates (while they were all circular, different coloring indicated their differences.
Tetracycline works by inhibiting the enzyme reactions that allows for necessary cell processes including protein synthesis in bacteria (Klajn). Many different bacteria are sensitive to tetracycline, including large viruses, both gram negative and gram positive bacteria, spirochettes, and richettsia. It is used to treat many diseases and bacterial infections, including E. Coli, bronchitis, and the plague. However, due to its long-spread use in medicine, many bacteria have mutated and become resistant to tetracycline.
Part 3:
The purpose of this procedure is to observe morphological characteristics of two different colonies of bacteria from nutrient plates and one colony from a Tet-treated plate in the hopes of identifying the bacteria. These three samples will also be used in PCR reactions to obtain material for DNA sequencing to better identify the bacteria species; then the known species can be matched with its observed morphological characteristics.
Results:
Colony Label: 10^-9 nutrient agar
T-treated: No
Gram Neg or Pos: Negative
Colony Description: Filamentous; creamy white/yellow
3 Colonies: 3
Cell Description: Motility: sessile. Cocci arrangement. Bacteria held close together in colony.
Colony Label: 10^-7 nutrient agar
T-treated: No
Gram Neg or Pos: Negative
Colony Description: Circular; white color
3 Colonies: 12
Cell Description: Motility: sessile. Magenta color at 40X. Cocchi shape looks like small air bubbles.
Colony Label: 10^-3 tet-treated agar
T-treated: Yes
Gram Neg or Pos: Both: Blue and Pink coloring indicate a mixture of bacteria species in this sample
Colony Description: Circular; clear/white color
3 Colonies: 53
Cell Description: Motility: Jumping about. Cocci rods and spirilium arrangements.
Conclusions:
Based on the results from the DNA sequencing, we have determined these three bacteria samples as the following species:
Colony label: 10^-9 nutrient agar
Species: Bacterium 28W314
Colony label: 10^-7 nutrient agar
Species: Uncultured bacterium clone WIR21Powerf11_8819
Colony label: 10^-3 T-treated agar
Species: Chryseobacterium sp. StRB028
The most reliable tool for bacteria identification is DNA sequencing; however, sequencing doesn't always work, as seen in the second of the three colony samples which was identified as an uncultured bacteria. In that instance, returning to morphological characteristics can help narrow down the possibilities of what the bacteria may be. The third colony sample is chryseobacterium, which is considered a gram negative bacteria, indicating that the gram positive cells observed must have been a different species or a contamination of the sample.
Works Cited
Klajn, Rafal. "Tetracycline: Antimicrobial Properties." Institute of Organic Chemistry. PAN. http://www.chm.bris.ac.uk/motm/tetracycline/antimicr.htm (accessed Mar 2, 2014).
Lab 4
Part 1: Plants
The purpose of this experiment is to determine what types or plants can be found in our transect, and to learn about the varying characteristics of plants.
Procedure:
1) Go to Transect 5 and select 5 diverse types of plant parts. Be sure to minimally affect the environment; do not tear or take live plant matter off of plants.
2) Take photos of any of the trees that are on the transect or surrounding it which may drop leaves onto the transect.
3) Include at least one flower or seed in of seeded plant.
4) Describe the plants; in the lab, try to determine their Genus. Record their type of vascularization, and the shape, size, and cluster arrangement of leaves for each plant. Determine whether any seeds are monocot or diocot.
Results:
- 1 Group and Genus: The group is an angiosperm and the genus is Rosa
Location: Underneath of a rose bush in the soil.
Description: Leaf, presumably from the rosebush as it matches the leaves on the rosebush.
Vascularization: Coming form an angiosperm, this leaf has specialized vascularization, including phloem and xylem. The bush must then have roots.
Leaves and special characteristics: The leaf has vascularization and is a simple leaf. It has an oval shape with one pointed end, and slight ridging along the edge of the leaf.
Seeds/ Evidence of flowers: Reproductive Characteristics: The leaf indicates that it comes from a dicot plant because its veins (xylem and phloem) begin at the base but branch out over the leaf, unlike monocots that have straight veins from the base to the tip of the leaf.
- 2 Group and Genus: The group is Angiosperm and the Genus is Quercus.
Location: In the grass.
Description: A Leaf, discovered to be from the Black Oak tree.
Vascularization: The leaves had major veins traveling into each spiny lobe from a central vein. Very tiny veins branched off of these secondary veins.
Leaves and special characteristics: The simple leaf had 6 spiny lobes. It's appearance led us to believe it was an oak leaf, and we determined it was a Black Oak leaf because the description said black oak leaves have 5-7 spiny lobes.
Seeds/ Evidence of flowers: Reproductive Characteristics: The Black Oak tree has acorn seeds. An acorn from the tree was our third plant matter collected. See below for info on the acorns dicot status.
- 3 Group and Genus: The Group is angiosperm and the Genus is Quercus.
Location: On the ground at the border between the soil and the grass.
Description: A small, squat brown acorn with a round top and short stem.
Vascularization: There was no vascularization visible in the acorn, as it is a seed.
Leaves and special characteristics: The leaf characteristics were not visible in the acorn; however, leaf and vascularization specifics of Black Oak trees can be found above in the second example of plant matter found in the transect.
Seeds/ Evidence of flowers: Reproductive Characteristics: The acorn indicates that this plant is a dicot, because leaves the branch out of the seed are symmetric, with one leaf on each side of the stem.
- 4 Group and Genus: The group is Angiosperm and the Genus is Rosa.
Location: In the soil underneath of the rosebush.
Description: Flower, presumably from the rosebush given its similar appearance to flowers still attached to the bush.
Vascularization: The flower does not have examples of vascularization, but see the description of the first plant matter example for details on Rosa.
Leaves and special characteristics: No leaves are visible but information on the Rosa leaves is available in the first plant matter sample.
Seeds/ Evidence of flowers: Reproductive Characteristics: The flower shows that the plant is an angiosperm. Monocots have 3 petals on the flowers and dicots have 4-5 petals; this flower had 5 petals, so it shows that the plant is dicot.
- 5 Group and Genus: Group: The group is angiosperm and the Genus is probably Agrostis, as this Genus contains many lawn grasses.
Location: Pulled gently from the patch of grass.
Description: Short, thin green grass.
Vascularization: There are veins that run from the base to the tip of the blades of grass.
Leaves and special characteristics: The glades of grass are the leaves; they are simple leaves with strait lines of vascularization. Blades are apx. 15 cm long.
Seeds/ Evidence of flowers: Reproductive Characteristics: The vascularization indicates that grass is monocot.
Here is a photo of the 5 plant matters sampled:

Conclusions: One can decide characteristics of plants based on small parts. By observing a leaf's vascularization, one can determine whether is it dicot or monocot, thus determining the number of cotyledons in the seed. Types of vascularization and leaves also determine what group the plant falls into (examples of vascularization hint at a plants structure). One can determine the Genus and even species of a plant based from observing partial characteristics, especially with the use of keys such as this one which helped determine that two leaves from the transect came from the Black oak tree.

Part 2: Fungi
The purpose of this experiment is to determine the dividing characteristics of the three types of fungi, and to be able to identify these different characteristics in samples.
The purpose of fungi sporangia are to produce spores in fungi; they are the "fruitful" parts of Fungi. Fungi reproduction is asexual.
This sample of the three sample fungi is zygomycota, as it has sporangia, is terrestrial, and the hyphae fialments lead me to determine that this is black bread mold. Here is a photo through the dissecting microscope:

Conclusions: Fungi are most notably different through their general shape - whether they form a solid standing shape or are filamentous, for example - and their type of spores or reproductive bodies.
Lab 5:
The purpose of this experiment is to learn about the varying characteristics of invertebrates. Each subpart has its own goal.
Part 1:
The purpose of this part is to learn about the different movements in the three types of worms, and how these movements are related to the worms' body structure.
The acoelomate seems to glide along the bottom of the petri dish. The worm is flat and tick, but small. It looks like a leech. It also has no body cavity.
The coelomate can inch forward by contracting and retracting forward. The worm is thick and long and large. It appears to be full of muscle, which coincides with the fact this it has an internal body cavity which must be protected when moving. The muscles in this worm allow it to lift upright like a snake rearing up.
The pseudocoelmate had no observed movement in the sample provided.The worms are small and thin. The body cavity is not formed through gastrulation.
Part 2.
The purpose of this experiment is to be able to identify invertebrates from the transect using an identification key which observes characteristics such as any and what type of wings are present, leg shape, and the number of body regions/parts.
Procedure:
1) Make a petri dish from water collected at the bottom on the tube and another petri dish with water from the top of the tube.
\
2) Select 5 animals from between the two petri dishes. Observe with a dissecting microscope.
3) Measure the length of the organisms.
4) Describe the organism and try to identify it by using a dichotomous key of common invertebrates.
Results:
Kind of organism (determined with dichotomous key): Fly
Length in mm: less than 1 mm
Brief Description: 1 set of black wings, black, small
Kind of organism (determined with dichotomous key): Beetle
Length in mm: 2 mm
Brief Description: Dark brown, shell like wings covering back. Two body regions visible (head and body). Two antennae.
The beetle can be observed in Figure 1:

Kind of organism (determined with comparisons to pictures in lab): Springtail primitive insect
Length in mm: less than 1 mm
Brief Description: 6 legs, a head and body visible. Two antennae and a tail-like profusion at its rear end.
The Spingtail Primitive Insect and Fly can be observed in Figure 2:

Kind of organism (determined with dichotomous key): Centipede
Length in mm: apx. 10 mm
Brief Description: Long and curved symmetrical body with many segments.
Kind of organism (determined with dichotomous key): Ground Spider
Length in mm: Less than 1 mm
Brief Description: 8 legs, clear/translucent, almost white body, holding prey in spun sac in its legs.
The ground spider and centipede can be seen in Figure 3:

Conclusions:
The organisms ranged in size from less than a mm, needing a dissecting microscope to observe them, to almost a centimeter in length. The millipede was the alrgest organism and the springtail primitive insect was the smallest. The most common insects in leaf litter are larger and include spiders, millipedes, and centipedes; reasoning behind this could be that larger animals have more diversified or developed eating mechanisms which better allow them to find nutrients in leaf litter rather than soil.
Part 3:
The purpose of this part of the experiment is to be able to identify which vertebrates may live in or pass through the transect based on its plant and invertebrate species.
Conclusion:
Vertebrate 1: Eastern Gray Squirrel
Phylum: Cordata
Class: Mammalia
Order: Rodentia
Family: Sciuridae
Genus: Sciurus
Species: carolinensis
Beneficial Biotic Characteristics of Transect: The presence of acorns, a useful food source for squirrels, especially during hibernation. Nearby black oak tree provides shelter and a course of acorns.
Beneficial Abiotic Characteristics of Transect: The mild climate allows squirrels to abound in Washington DC.
Vertebrate 2: Wood Thrush
Phylum: Chordata
Class: Aves
Order: Passeriformes
Family: Turdidae
Genus:Hylochicla
Species: mustelina
Beneficial Biotic Characteristics of Transect: The animal feeds on invertebrates, primarily insects, which are found abundantly in the leaf litter and soil of the transect.
Beneficial Abiotic Characteristics of Transect: The temperate climate is ideal for the small bird. Moist soil and leaf litter is a must for the birds' feeding habits.
Vertebrate 3: American Robin
Phylum: Chordata
Class: Aves
Order: Passeriformes
Family: Turdidae
Genus: Turdus
Species: migratorius
Beneficial Biotic Characteristics of Transect: There are many invertebrates in the transect which allow for ample food opportunities. nearby trees allow for habitat opportunities, especially when breeding and raising babies.
Beneficial Abiotic Characteristics of Transect: The bird can both live year-round and breed in the temperate climate of the mid-atlantic and Northeast, including that of this transect in DC.
Vertebrate 4: White-Footed Mouse
Phylum: Chordata
Class: Mammalia
Order: Rodentia
Family: Cricetidae
Genus: Peromyscus
Species: leucopus
Beneficial Biotic Characteristics of Transect: Mice eat available vegetation, making the fruits and seeds in the soil of the transect a good source of food.
Beneficial Abiotic Characteristics of Transect: The mild climate allows for roaming in the spring and summer and hibernation in the soil or under the grass, in the ground, during fall and winter.
Vertebrate 5: Brown Rat
Phylum: Chordata
Class:Mammalia
Order: Rodentia
Family: Muridae
Genus:Rattus
Species: norvegicus
Beneficial Biotic Characteristics of Transect:These omnivores will eat both the invertebrates and the seeds found in the transect, particularly in the leaf litter and soil.
Beneficial Abiotic Characteristics of Transect: The mild climate is ideal for rats just as it is for mice.
Figure 4 contains a Food Web which attempts to connect the many different organisms found in Transect 5:

Lab 6: Zebrafish Embryology
The purpose of this experiment is to observe the development of zebrafish embryos and to determine what effect a salinated aquatic environment has on their development. Based on the article "Effet of Salinity on Development of Zebrafish, Brachydanio rerio," by M. S. Sawant, S. Zhang, and L. Li, we hypothesized that once zebrafish development passes gastrulation, water salinity less than 4% does not affect the growth of zebrafish embryos. We predicted that, since our eggs were entering organogenesis in the 40th to 42nd hour of development, a 3% salinity would not affect growth or nuclear division.
Methods and Materials:
1) Zebrafish eggs were fertilized to create clear, healthy embryos.
2) Two days after fertilization, between the 40th and 42nd hour of development, at least 20 eggs each were injected into 4 different petri dish samples:
a) a Control sample of 20 mL of Deerpark water
b) 20 mL of 0.03 % saline solution made from Deerpark water mixed with 3 % NaCl solution
c) 20 mL of 0.30 % saline solution made from Deerpark water mixed with 3 % NaCl solution
d) 20 mL of 3.0 % saline solution made from Deerpark water mixed with 3 % NaCl solution
3) The 4 samples populations were placed in a cool, dry location in the lab, exposed equally to the lighting and temperature of the lab.
4) The samples were checked on day 4, 7, 10, and 14 of the experiment. Due to the fact that paramecium were not fed to sustain the larvae, the experiment ends on day 7, as day 10 saw the beginning of culling due to starvation. At each check-in, several samples were fixed in paraformaldehyde.
5) At the day 4 check-in, the following was recorded:
a)number of live, unhatched eggs.
b) number of unhatched, dead eggs
c) number of hatched, dead larvae
d) number of hatched, alive larvae
6) After counting, the dead embryos were removed. Additional solution was added if the samples were drying out.
7) At day 7 check-in, the above was recorded, as well as:
a) movement based on this quantitative scale:
0) no movement, presumed dead
1) move tail only when directly prodded
2) swim away only when directly prodded
3) move only tail when water disturbed
4) swim around only when water is disturbed
5) Minority of live larvae swimming around on own free volition
6) Majority of live larvae swimming around on own free volition
b) The heart-rate of the fish on avg.
c) The length of the fish from head to the tip of their tails on avg.
d) The diameter of their eyes on avg.
Results:
Day 4 Check-in:

Control Sample:
4 un-hatched, dead egg embryos.
0 un-hatched, alive egg embryos
5 hatched, dead embryos
40 hatched, alive embryos
Movement: 6

.03% Salinity Sample:
2 unhatched, dead egg embryos
0 unhatched, alive egg embryos
4 hatched, dead larvae
20-21 hatched, alive larvae
Movement: 5

0.3 % Salinity Sample:
1 unhatched, dead egg embryo
0 unhatched, alive egg embryos
2 hatched, dead larvae
28-30 hatched, alive larvae
Movement: 4
3.0 % Salinity Sample:
25 hatched, dead larvae
Movement: 0 - dead & sessile

Day 7 check-in:
Control Sample:
0 un-hatched, dead egg embryos.
0 un-hatched, alive egg embryos
0 hatched, dead embryos
40 hatched, alive embryos
Movement: 5, very fast swimmers when provoked
Heart-rate: 54 bbm
Body length: 400 micrometers
Eye diameter: 28 micrometers
Yolk sac is absorbed; no longer visible



.03% Salinity Sample:
0 unhatched, dead egg embryos
0 unhatched, alive egg embryos
0 hatched, dead larvae
23 hatched, alive larvae
Movement: 5
Heart-rate: 78 bbm
Body length: 338 micrometers
Eye diameter: 28 micrometers
Yolk sac is absorbed; no longer visible

0.3 % Salinity Sample:
0 unhatched, dead egg embryo
0 unhatched, alive egg embryos
8 hatched, dead larvae
18 hatched, alive larvae
Movement: 3; Unprovoked, their tails twitch and their eyes move; otherwise, they only swim when water is disturbed excluding several acceptions which swim of their own volition
Heart-rate: 114 bbm
Body length: 400 micrometers
Eye diameter: 30 micrometers
Yolk sac is absorbed; no longer visible
File:Say7sample3.jpg
3.0 % Salinity Sample:
23 hatched, dead larvae; dead larvae were not removed from the last check-in; presumed that 2 degraded in the past 3 days
Movement: 0 - dead & sessile
Heart-rate: 0 bbm
Body length: 188 micrometers; curved body as though still wrapped around a yolk sac
Eye diameter: 28 micrometers; only one eye observable; hole in head where other eye should be

Conclusions:
Both the hypothesis and prediction appear wrong, seeing that the salinity of the water, less than 4%, did affect embryo development. This is best seen in the 3% solution sample: The fixed sample on day 7 was half the length of the other 3 samples and curved as though still around a yolk sac. Presuming that the yolk sack degraded in the fixing process, the samples in the 3% solution never developed enough to absorb their yolk sacs.
On both day 4 and day 7, as the salinity rose, the quantitated movement values lowered, indicating that the saltier the water, the slower the fish swim. On day 4, movement lowered with each sample, from 6 in the control sample, to 5 in the .03% sample, to 4 in the 0.3% sample. Likewise, on day 7, movement lowered with each sample, from 5 in the control sample and .03% sample, to 3 in the .3% sample.This may indicate an affect on the salt on the development of either the tail and fins, or, more likely given the visible health of these body parts, issues in brain development leading to slower or less neuron firing, and thus slower reactions and movements.
The salt may also have affected basic body functions, thus requiring the fish to use more energy on basic functions such as pumping their hearts, and less energy on swimming. On day 7, the higher the salt concentration, the higher the fishes' hearts' beats per minute: 54 bpm for the control group raised to 78 bpm for the .03% group raised to 114 bpm for the 0.3% group. The higher salt concentration could have affected the development of the heart, or the ability of the fish to extract oxygen from the water, requiring higher fast rates to absorb an amount of oxygen necessary for life. As the energy expended on the heart and circulatory system rises, the energy supplied to swimming would have declined.
The length measurements from day 7 indicates little change in the growth of the fish of the control, .03%, and .3% samples; while the .03% sample had a shorter body than the control sample, the control sample and the .3% sample had the same body length, and all three samples had relatively equal eye diameters. Given the relatively low salinity, I determine that while low levels of salinity may affect brain development or basic bodily functions, it does not affect the growth in terms of what stage of development the fish may reach due to cell division and mitosis. However, the halving of the 3.0% sample's body length indicates that major levels of salinity - 3% in this case, which approaches the 4% level from Sawant, Yang, and Li's experiment - do affect cell division and not only prevent growth, but certainly lead to death, as by day 4 all of the larvae were dead.
While less than 1% salinity might not affect fish growth, the decreasing number of live larvae in these three samples on both day 4 and 7 indicate that something related to the salinity lead to larvae death. Larvae death before day 4 could have been caused by any number of average developmental problems. Since no larvae died in the control or .03% sample between day 4 and 7, but the 0.3% sample did experience deaths, the deaths can be linked to the rising level of salinity. The declining levels of bodily functions, due to the salinity, may have caused these deaths. Rising heart-rates in the samples would lead to a faster consumption of food fro the yolk sac, leading to faster instances of death by starvation in the samples with a higher heart-rate.
Overall, this experiment found that salinity levels below 1% do not affect fish development, but do affect the basic functions of the fish, including the rate of circulation of oxygen and movement. Salinity rates above 1%, particularly approaching 4%, do affect cell growth and embryo development. This experiment exhibits why zebrafish are freshwater fish - they function best in low-salinity environments.
Those who perform this experiment in the future should provide paramecium as food on day 7. They should control the temperature of the lab, as warmer days in the lab lead to increased activity and consumption of the yolk sac. They might want to consider beginning the experiment at an earlier stage of development, before hours 40-42. They also may want to consider a sample group with a salinity around 1% and 2%, to get a better idea of what salinity level begins to affect cell growth and embryo development.
This experiment is useful because it indicates that pollution which may affect salinity levels of freshwater aquatic environments affect the livelihood and development of freshwater species. Since it only takes the elimination of one species to disrupt a food chain, niche, or entire ecosystem, protecting the salinity levels in freshwater habitats is vital to the biodiversity and continuation of these environments.